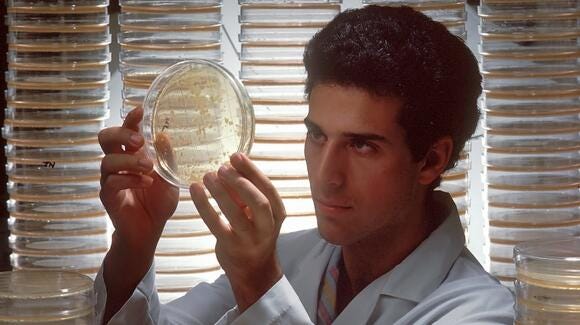

Fight Against Lupus: Two Biotech Companies Announce This Partnership
Groundbreaking Partnership Between Lupus Therapeutics and Nkarta Inc. for Lupus Nephritis
Groundbreaking Partnership Between Lupus Therapeutics and Nkarta Inc. for Lupus Nephritis
In a groundbreaking development, Lupus Therapeutics, the clinical research affiliate of the Lupus Research Alliance, announced a partnership with Nkarta Inc. (Nasdaq: NKTX), a leading biopharmaceutical company. This collaboration aims to support the evaluation of Natural Killer (NK) cell therapy in Lupus Nephritis, a significant advancement in the fight against this debilitating condition.
Nkarta Inc., a biopharmaceutical company listed on NASDAQ under the ticker symbol "NKTX", is renowned for developing novel NK cell therapies for cancer patients. Its pioneering work in the field of cell therapy has garnered attention from various quarters in the medical community.
On the other hand, Lupus Therapeutics, an affiliate of the Lupus Research Alliance, is dedicated to finding safer, more effective treatments for lupus. Its mission is to transform treatment while advancing towards a cure by uniting the global lupus community in bold, innovative research endeavors.
The Collaboration
The partnership between Nkarta Inc. and Lupus Therapeutics aims to evaluate the potential of NK cell therapy in treating Lupus Nephritis. Known as NKX019, the specialized NK cell therapy under development is designed specifically for patients with refractory diseases.
News of the partnership led to a significant surge in Nkarta's shares, underscoring the market's optimism about the potential of this collaboration. The FDA's clearance of the IND for Lupus drug further bolstered this sentiment.
Potential Impact on Lupus Nephritis Treatment
Lupus Nephritis, a form of lupus that causes inflammation in the kidneys, can be challenging to treat. The collaboration between Lupus Therapeutics and Nkarta Inc. promises to usher in a new era in the treatment of this condition.
By leveraging the power of NK cell therapy, the partnership aims to provide a more effective treatment option for Lupus Nephritis patients. If successful, this could significantly improve the quality of life for patients and potentially pave the way for further advancements in lupus treatment.
The Road Ahead
While the partnership is certainly a major step forward, it's important to remember that the journey is just beginning. The evaluation of NK cell therapy in Lupus Nephritis will require careful research and clinical trials to ensure its safety and efficacy.
However, the collaboration between Lupus Therapeutics and Nkarta Inc. is undoubtedly a promising development in the fight against Lupus Nephritis. It offers hope for millions of patients worldwide who are eagerly waiting for more effective treatment options.
In conclusion, the partnership between Lupus Therapeutics and Nkarta Inc. marks a significant milestone in the battle against Lupus Nephritis. By exploring the potential of NK cell therapy, this collaboration could potentially transform the treatment landscape for this debilitating condition.
Disclaimer: This article is intended for informational purposes only. It is based on facts and information publicly made available by Lupus Therapeutics and Nkarta Inc. The author does not hold any position in Nkarta Inc. or any other mentioned company and has no plans to initiate any positions within the next 72 hours.
As an investor it's important to stay updated with major news by creating an account.
Sources: